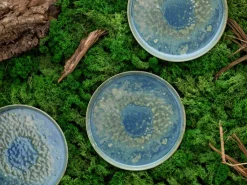
CreaTable Speiseteller YUKI 6er Set 28 cm Hochwertiges Steinzeug

Setartikel: jaAnzahl Setartikel: 6 Stk.
Eigenschaften Fachsortimente: mikrowellengeeignet
Farbe: BlauGelbGrünHauptfarbe: Blau
im Lieferumfang enthalten PORTA: 6 Speiseteller lt. Ausstattung/ZubehörZusatzhinweise PORTA: Bitte die Hinweise an der Ware beachten.Bitte die Pflegeanleitung an der Ware beachten.Lieferhinweise PORTA: Alle Maße sind circa Angaben. Geringfügige Abweichungen sind möglich.Die Lieferung erfolgt je nach Artikelart frei Verwendungsstelle, frei Bordsteinkannte auf einer Einwegpalette oder als Paket. Bitte trage Sorge dafür, dass am vereinbarten Speditionsliefertermin die Ware entgegengenommen werden kann.Lieferhinweis: ohne Dekoration
Marke: Creatable
Material: KeramikKeramikart: Feinsteinzeug
Höhe: 3 cmGewicht: 0,9 kg
Der Anblick der 6 Speiseteller aus dem CreaTable Set YUKI weckt Assoziationen an die blau-grünen Tiefen der Ozeane. Die außergewöhnliche Farbgebung kommt auf einem weißen Tischtuch oder einer hellen Tischoberfläche besonders gut zur Geltung. Jeder der Teller hat einen Durchmesser von 28 cm und ist somit für das Mittag- oder Abendessen geeignet.
Das Set YUKI enthält 6 Speiseteller aus hochwertigem Feinsteinzeug. Es lässt sich auf Wunsch mit weiteren Geschirrteilen der gleichnamigen Serie ergänzen. Der nach oben gezogene Rand gibt dem Service seinen besonderen Look und sorgt gleichzeitig dafür, dass cremige Soßen auf dem Teller bleiben. Das Geschirr mit dem ausgezeichneten Design ist spülmaschinenfest.

Reviews
There are no reviews yet.